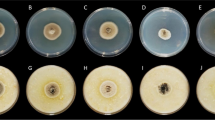

Abstract
Due to climate change, Neofusicoccum parvum is currently emerging as a new pathogen of Rosaceae plant species. This increases the need of gaining knowledge on the pathogenicity of this fungus, particularly on apple cultivars of considerable economic importance. In this study, the virulence and temperature dependence of N. parvum isolates was assayed on ‘Gala’ and ‘Fuji’ apple fruit and wood. At 25 °C and 30 °C, ‘Gala’ fruits showed a higher susceptibility to all fungal strains than ‘Fuji’, whereas low infection severity was shown at 15 °C and 20 °C on both cultivars. Infrared spectroscopy revealed that ‘Fuji’ fruit tissues displayed a higher content of phenolic compounds and pectin esterification degree, as factors possibly correlated with fruit susceptibility. When strain virulence was assayed on wood, no significant difference in susceptibility was detected, as also shown by SEM analysis. The virulence of N. parvum was also tested by assaying the activity of lytic enzymes such as cellulase, polygalacturonase, polymethylgalacturonase, and xylanase.
Similar content being viewed by others
Avoid common mistakes on your manuscript.
Introduction
Botryosphaeriaceae (Theiss & P. Syd.) are cosmopolitan fungal species pathogens of a broad range of both annual and perennial plant hosts (Slippers and Wingfield 2007). The taxonomy of Botryosphaeriaceae is complex and distinction of members based on morphological aspects is very difficult due to the high similarity among species (e.g. Botryosphaeria (Ces. & De Not.)) and Neofusicoccum (Crous, Slippers and Phillips) species produce very similar conidia (Phillips et al. 2013). For this reason, molecular analyses are often required for species identification (Slippers et al. 2013). On the other hand, pathogens belonging to this family can grow fast on fruit crops, causing significant economic losses worldwide (Coakley et al. 1999). Among Botryosphaeriaceae species reported to be pathogenic in fruit crops, Neofusicoccum parvum is one of the common species, in warmer geographical areas (Úrbez-Torres 2011; Sakalidis et al. 2013). Some years ago, Sakalidis et al. (2013) confirmed the widespread diffusion of N. parvum showing its virulence on about 90 plant hosts worldwide. Generally, N. parvum is reported as the causal agent of grapevine dieback (Úrbez-Torres 2011; Taylor et al. 2005; Luque et al. 2009; Spagnolo et al. 2014) causing plant losses up to 50% (Bertsch et al. 2013). In particular, N. parvum symptoms are associated with orange/brown stripes located in the longitudinal direction in the outer xylem of wood plants. These symptoms are often associated with the foliar symptoms (Mugnai et al. 1999) suggesting that the pathogen is capable of producing phytotoxic metabolites which can migrate systemically into the host plant. Botryosphaeriaceae can cause severe symptoms also in apple fruit consisting of a soft light-colored rot called “white rot” (Khon and Hendrix 1983). In Brazil, N. parvum is recognized as an emerging pathogen for apple crops, raising concerns about protection strategies (Melzer and Berton 1986; Hansen et al. 2007). Nevertheless, its ecological role in plant communities is poorly studied (Slippers et al. 2007).
In order to gain knowledge on the infection mechanism of this fungus in apple tree and fruit we set out to study the virulence of five N. parvum Brazilian strains at different temperatures and on different cultivars by in vitro and in vivo assays respectively. Scanning Electron Microscopy (SEM) was performed on apple twigs artificially infected with the pathogen in order to assess the infection timings. The activities of major lytic enzymes were quantified by in vitro agar plate assays and infrared spectroscopy analysis of infected apples was performed to detect metabolic profiles likely associated with cultivar susceptibility.
Materials and methods
Pathogen
After field observations, N. parvum strains were isolated from cankers of internal wood necrosis of ‘Gala’ apple trees, located in different experimental orchards of the State University of Mid-Western of Paraná (Brazil) (Supplemental Fig. 1). Wood necrotic parts were inoculated on Potato Dextrose Agar (PDA, 39 g L−1 of distilled water) (Sigma, St. Louis, MO, USA) at 25 °C for 5 d. Then, fungi were morphologically selected, purified and grown on Malt Extract Agar plates (MEA, 50 g L−1 of distilled water) (Sigma, St. Louis, MO, USA). From each experimental orchard, three pure cultures were isolated.
The strains NP1, NP2, NP3, NP4, and NP5 were selected for their high virulence on apple fruit and identified by morphological analysis and sequencing of ribosomal DNA ITS regions. PCR was performed using universal primers ITS1 (GCCGTAGGTGAACCTGCGG) and ITS4 (GCCTCCGCTT ATTGATATGC) directly from mycelia in pure culture, using the protocol described by Iotti and Zambonelli (2006). PCR reactions were conducted in 50 μL volume reactions containing 10 mM TrisHCl (pH 8.3), 50 mM KCl, 1.5 mM MgCl2, 150 μM of each dNTP, 300 μM of each primer, and 1.5 U of TaKaRa Taq DNA polymerase (Takara, Otsu, Japan). Twenty micrograms of Bovine Serum Albumin (BSA) (Fermentas, Vilnius, Lithuania) were added to the reaction tubes containing the mycelial fragments before adding the other PCR reagents. The amplification reactions were carried out in a T gradient thermal cycler (Biometra, Gottingen, Germany) with an initial denaturation at 95 °C for 6 min followed by 30 cycles of 94 °C for 30 s, 55 °C for 30 s, 72 °C for 1 min and a final step of 72 °C for 10 min. PCR products were run on 1% agarose gels, stained with ethidium bromide and visualized under UV light. The amplified DNA was purified by Nucleospin Extracts II Kit (Macherey–Nagel, Germany) and finally sequenced by Eurofins Genomics (Luxemburg). The ITS sequences were compared to those of the GenBank database (http://www.ncbi.nlm.nih.gov/BLAST/) using the BLASTN search.
Culture substrates
NP1, NP2, NP3, NP4, and NP5 strains were grown on MEA, Apple Agar (AA, 15 g agar technical and 250 mL of a commercial apple juice per 1000 mL of distilled water), PDA in Petri dishes (90 mm) with/without four autoclaved woody sticks (70 mm) (Supplemental Fig. 2) and incubated at 25 °C with 12-h dark and 12-h light cycles for 8 d, to verify the most suitable condition for conidia production. For each medium, 10 plates were considered as replicates.
Wood and fruit
Hardwood twigs of one year old (50 cm) were collected from ‘Fuji’ and ‘Gala’ plants of Bologna University experimental fields located in Cadriano (Bologna, Italy) in February 2018, stored at 5 °C and used for experiments within 5 d from collection. ‘Fuji’ and ‘Gala’ apples (Malus domestica L. Borkh) were obtained from an orchard located in Sala Bolognese (Bologna, Italy). Harvested fruits were stored at 0 °C and used for experiments within 5 d after harvest. Fruits were wounded by a sterile nail (3 × 3 × 3 mm) on the equator (one wound per fruit).
In vivo experiment: virulence in wood
One hundred and fifty twigs of ‘Gala’ and ‘Fuji’ apples were cut into 30 cm long segments, rinsed with tap water, surface disinfected with 70% alcohol and air dried. Three wounds were made between buds position on each twig using a sterile blade and a mycelium agar plug (4 mm in diameter) from a 8 d-old colony of each strain was placed in the wound and wrapped with sterile cotton wetted by 5 mL of sterile water and covered with Parafilm® (Pechiney Plastic Packaging, USA) (Fig. 1 a). For each apple cultivar, 15 twigs were inoculated with the above mentioned five fungal strains. Negative control was constituted by no inoculated twigs. Twigs were soaked in 200 mL of sterile water in upright position and incubated at room temperature (20 °C), with 12-h dark and 12-h light at 60% of relative humidity (RH). The lesions were evaluated 12 d after the inoculation and measured by the software ImageJ 1.x (Wisconsin, USA) (Schneider et al. 2012). Conidia from inoculated twigs of both apple cultivars were collected with 2 mL of distilled water and counted through a microscope (Nikon Eclipse TE2000-E). The experiment was repeated twice.
‘Gala’ apples twigs were wounded and inoculated with Neofusicoccum parvum (NP1 strain) mycelium agar plug, wrapped with sterile cotton wetted by 5 mL of sterile water and covered with Parafilm. After 12 d from the artificial inoculation are noticeable: pycnidia (a), conidia (14 μm length on average) (b) and symptoms (c)
Scanning Electron Microscope observation in wood
The virulence of N. parvum strain NP1 on wood was investigated with SEM observations of inoculated ‘Gala’ and ‘Fuji’ twigs as previously described. The control twigs were not inoculated. The SEM observations were carried out 3, 6, and 12 d after the twig inoculations. A little portion of tissue (3 × 3 × 3 mm), corresponding to the inoculated wound, was excised from treated twigs and observed under SEM (Zeiss DSM 962 microscope at 30 kV). Three samples from each twig were fixed in a phosphate buffer (pH 7.4) containing glutaraldehyde (3%). Before observation, the fixed tissues were rinsed three times with phosphate buffer (pH 7.4), dried by washing with increasing concentrations of ethanol, stuck on aluminium stubs, and coated with gold palladium (Di Francesco et al. 2017). Nine samples derived from three twigs of the same cv were examined for each sampling time (for a total of 54 samples).
In vivo experiment: virulence in apple fruit
Fungal virulence displayed by the isolate NP1 was also tested on apple fruit and the influence of different temperatures was assayed to evaluate the effect on the strain virulence on apples measured as lesion diameter.
‘Gala’ and ‘Fuji’ fruits were inoculated with N. parvum NP1 conidia suspensions (1 × 104 conidia mL−1). Conidial suspensions were prepared by washing N. parvum pycnidia, artificially inoculated on ‘Gala’ and ‘Fuji’ apple twigs, with sterile distilled water containing 0.05% (v/v) Tween 80, quantified with a hemocytometer and diluted to the required concentration.
Each fruit was wounded with a sterile needle and inoculated with 20 μL of a pathogen suspension. The control consisted of inoculated fruit with sterile water. Apples were kept at 15 °C, 20 °C, 25 °C and 30 °C at 90–95% RH. The lesion diameters were measured after 7 d from the inoculation. The experiment was conducted with 15 fruits per temperature and cultivar and was repeated twice (for a total of 480 fruits).
Neofusicoccum parvum pathogenesis enzyme activity
Cellulase (endo-1,4-β-glucanase), pectic enzyme (polygalacturonase and polymethylgalacturonase) and xylanase enzyme activities of N. parvum were evaluated 3, 9, 24, and 48 h after inoculation.
Assays were performed in Petri dishes containing modified agar medium (Di Francesco et al. 2018). Three mycelium plugs (4 mm) from 8 d-old fungal colony were placed equidistant in the medium. Control plates for each enzyme-pathogen combination were inoculated with MEA plugs without mycelium. After incubation at 25 °C, enzymes activities were determined with specific colorimetric methods visualizing a clear zone of substrate degradation around the mycelium plugs. The diameter of degradation halos (mm) was measured with a ruler. For each incubation time for pathogen and control, four plates (replicates) were considered.
For cellulase activity, the agar medium consisted in PYE (peptone: 0.5 g; yeast extract: 0.1 g; agar: 16 g L−1) supplemented with 0.5% Na-carboxymethylcellulose (Sigma-Aldrich, St. Louis, MO, USA) (Mugnai et al. 1997). The halo produced by endo-1,4-β-glucanase activity of each fungus was visualized by staining plates with a 0.2% Congo red water solution for 15 min, then discolored with NaCl 1 M. Polygalacturonase activity was determined through the Eriksson and Pettersson culture medium (Eriksson and Petterson 1975) enriched with the sodium salt of polygalacturonic acid (Sigma-Aldrich) from citrus fruit (0.5%) and agarized with low calcium Oxoid No. 1 agar (2%, Oxoid, Basingstoke, UK). The medium was sterilized following the procedure of Ayers et al. (1966) and then the pH was adjusted to 5 and 8 respectively by adding NaOH 1 M. Polymethylgalacturonase activity was determined through the above cited culture medium enriched with Sigma citrus pectin (0.5%) and agarized with calcium-rich Oxoid No. 3 agar (2%). The growth media was sterilized following the procedure of Durrands and Cooper (1988) and the pH was adjusted to 8 by adding HCl 1 M. The halo produced by pectic enzyme activities was visualized by 1% cetylmethyl ammonium bromide (CTAB) dissolved in distilled water, heated to 30 °C. For the xylanase assay, the medium contained 0.5% beech wood xylan (Sigma-Aldrich) in a minimal medium consisting of NaNO3 0.3%; KH2PO4 0.1%; MgSO4 0.05%; yeast extract 0.1%; agar 1.2% (St Leger et al. 1997). The clearing halo was visualized by staining with Congo red, then de-stained with NaCl and measured as previously described. Each assay was repeated twice.
ATR spectroscopy
Three sterile flasks containing 50 mL of Malt Extract Broth (MEB, 50 g L−1 of distilled water) were inoculated each with 15 plugs of N. parvum NP1 mycelium 8 d-old, and incubated at 25 °C in a rotary shaker (250 rpm) for 8 d. The culture was centrifuged at 5000×g for 20 min at 4 °C and the mycelium was washed with distilled water and filtered through two layers of miracloth. Then, ‘Gala’ and ‘Fuji’ fruit slices (70 mm thickness) were inoculated with 1 g of N. parvum mycelium.
After 3, 9, 24, and 48 h, N. parvum mycelium was removed and apple slices were stored at −80 °C and suddenly lyophilized (FD-10 Freezing Dryer, Lab kits, H.K.) for 10 d to avoid water spectroscopic interferences. The control consisted in not inoculated apple slices.
The IR/ATR spectra of fruits at different times of both cultivars were compared in order to ascertain how N. parvum infection affected the chemical composition of fruits. Moreover, the IR/ATR spectra of the pulp of apple fruits displayed increasing differences compared to their control references with the inoculation time, therefore, only the longest inoculation time spectra are discussed.
IR spectra were recorded with a Bruker ALPHA series FT-IR spectrophotometer (Bruker, Ettlingen, Germany) equipped with a crystal diamond cell for attenuated total reflectance (ATR). The spectra were collected from 4000 to 400 cm−1 and averaged over 100 scans (resolution = 4 cm−1) on three different samples for each inoculation time.
Statistical analysis
Data were subjected to a one-way analysis of variance (ANOVA). Separation of means was performed using the least significant difference (LDS) test, at P < 0.05. Data were reported as mean values ± standard error (SE) of two independent experiments. All analyses were performed with the software Statgraphic Plus Version 2.1 (USA).
Results
Pathogen
The sequence analysis of the ITS rDNA regions identified the five pathogen strains used in this study as N. parvum with a sequence homology percentage of 99% with the relative accession number KY053054. The results of molecular characterization were compared with N. parvum morphological identification keys, showing a significant match.
Conidia production
Neofusicoccum parvum strains used in our tests, showed the ability to grow on different culture substrates, such as MEA, PDA, and Apple Agar. On these substrates, fungi grew very fast reaching complete colonization of the plate (90 mm) in only 5 d, however they did not produce pycnidia, in any of the different substrate (Table 1), even after 15 d (data not shown). On the other hand, when grown for 12 d on ‘Gala’ and ‘Fuji’ apple twigs (Fig. 1 a), all the strains produced pycnidia, but no statistical difference was detected among their concentrations, except for NP1 strain grown on ‘Gala’ apple twigs (Fig. 1 b and c and Table 1). At this incubation time (12 d), apple twigs showed great lesions only in correspondence of the fungus inoculation point and a large amount of black pycnidia appeared under the Parafilm layer (Fig. 1 a, b). Pycnidia derived from wood lesions contained conidia of an average length of 14 μm, without showing statistically significant differences between the two apple cultivars (data not shown). On the contrary, statistically significant difference was shown between conidia concentration detected on ‘Gala’ and ‘Fuji’ twigs (Table 1), with the first cultivar (‘Gala’) resulting the most suitable substrate for the pathogen strains (3.07 × 104 conidia mL−1 on average). The obtained conidia were inoculated on MEA plate and the mycelium growth and morphology were very similar to those of the original N. parvum isolates inoculated on twigs. After 8 d of incubation in MEA plates, mycelium plugs were placed on artificial wounds of new apple twigs treated as above and similar wood lesions after 12 d were detected containing pycnidia, fully satisfying Koch’s postulates, and supporting protocol reproducibility. The N. parvum isolates similarly colonized woody tissues of the two tested apple cultivars. After 12 d, blackish-brown discolorations were observed on woody tissues of both apple cultivars twigs (Fig. 1 c). Lesions were equally extended (about 20 mm2) in both cultivars. No clear and significant pathogenicity/virulence difference in the inoculated twigs was detected among the tested strains, and for this reason, one strain (NP1) for subsequent analyses was chosen.
SEM analysis
Scanning Electron Microscopy (SEM) observations of ‘Gala’ and ‘Fuji’ apple twigs inoculated with N. parvum NP1, revealed that after 3 d of incubation at 25 °C the pathogen started to germinate and colonize the tissue surface (Fig. 2 Aa). At 6 d (Fig. 2 Ab) after inoculation the SEM observations displayed a great increase of the mycelium with respect to the 3th day. In addition, the scanning observation at higher magnification (500 ×) emphasized the difference between the healthy and the tissue colonized by the fungus (Fig. 4 **panel).
Scanning electron micrographs (SEM) of ‘Gala’ (A) and ‘Fuji’ (B) twigs (surface and cross section) inoculated and not (Control) with Neofusicoccum parvum NP1 strain at different times from the inoculation (3d (a), 6d (b), 12d (c)). SEM shown, 200 x magnification in all images. *Specifics of the hyphae fungus penetration in twig tissue at 3 d from the artificial inoculation.**Specifics (500 ×) of the hyphae fungus colonization in twig tissue at 6 d from the artificial inoculation. Light blue arrows pointed NP1 mycelium
Six days later (Fig. 2 Ac), the pathogen hyphae already severely invaded the twigs tissues (cross section). No differences were observed between ‘Gala’ and ‘Fuji’ twigs about the N. parvum virulence (Fig. 2B (a, b, c)).
Virulence on apple fruit
After 7 d, the strain NP1 did not show any disease symptoms at 15 °C on both apple cultivars, whereas at 30 °C the fungal pathogen displayed the highest severity (60 mm and 71 mm for ‘Fuji’ and ‘Gala’ respectively) (Fig. 3). Moreover, NP1 displayed a higher virulence in ‘Gala’ apples with respect to ‘Fuji’ both at 25 °C and 30 °C. The fungus pathogenicity was limited at 20 °C.
Lesion diameter (mm) of Neofusiccoccum parvum NPI strain on apple fruit artificially inoculated after one week. Fruit wounds were inoculated with 20 μL of Neofusicoccum parvum conidia suspension (104 conidia mL−1). Fruits were kept at 15°C, 20°C, 25°C and 30°C for 7 d. Data are the means of fruits for each incubation temperature. Lower case: analysis per cultivar - Upper case: analysis between cultivar; different letters indicate significant differences according to LSD test, P < 0.05
Enzymes activity
The pectinase, polygalacturonase, xylanase, and cellulase pathogenesis enzymes activity of N. parvum strain NP1 was evaluated after 3, 9, 24 and 48 h of fungal growth. All the examined fungal enzyme activities started to be detectable at 3 h from the inoculation on the substrate, gradually increasing in time. At 24 and 48 h from the inoculation, the fungal strain showed the highest enzymes activity (Fig. 4). Xylanase resulted the highest enzymatic activity with respect to the other, displaying a very intense and large halo areas, already from 3 h of inoculation (200 mm2). Only cellulase activity appeared to decrease after 48 h from the inoculation. On the other hand, pectinase resulted in the tested fungal time of growth the lowest enzymatic activity with respect to the others CWDEs.
Polygalacturonase (PGL), Pectinase (PEC), Cellulase (CEL) and Xylanase (X 1 IL) activity (halo-cm2) of Neofusicoccum parvum NP1, after 3h, 9 h, 24 h and 48 h of incubation at 25°C. Each value is the mean of three replicates ± standard errors. Data were analyzed for significant differences (P < 0.05) by analysis of variance (ANOVA) followed by LSD test. Within the same enzyme the same letters represent no significant differences according to LSD test (P < 0.05)
ATR spectroscopy
IR/ATR spectra gave useful information to gain insight the chemical variation of affected fruits. In particular, the ratio between the peaks areas centered at 1730 and 1610 cm−1 was used to monitor the esterification degree of pectins (Supplemental Fig. 3). Figure 5 shows the spectrum of ‘Gala’ slices after 48 h from inoculation (in black) and the spectrum difference between this and the control at the same time (in blue). Positive peaks in the difference spectrum can be correlated to an increased concentration of phytochemical compounds, while a negative peak is related to a decreased concentration. Actually, several peaks related to the esterification degree of pectins turned out to be positive in the difference spectrum: 1737, 1370, 1280, 1231, 1119, 991 and 799 cm−1. More in detail, the peaks at 1737 and 1119 cm−1 are typical of acetylated pectins, whose concentration increases in infected ‘Gala’ apples compared to control. Moreover, other bands attributable to pectin vibrations changed their relative intensities or their wavenumber (Synytsya et al. 2003): 1406, 1343, 1252, 1141, 1080 and 964 cm−1, indicating chemical changes into pectin structure induced by the fungal presence. On the other hand, peaks related to phenolic compounds (i.e. flavonoids, lignins and ferulate esters) showed a marked decrease with respect to the control: in particular the bands at 1594 and 1182 cm−1 (Heneczowski et al. 2001).
‘Fuji’ apples’ spectrum after 48 h from inoculation, showed other variations in the difference spectrum (blue spectrum, Fig. 6), indicating different chemical variations induced by fungal attack. For example, the esterification degree of pectins decreased (Synytsya et al. 2003): 1739, 1274, 1117, 989, 929 and 834 cm−1 bands showed a negative peak. Some of these peaks indicate that pectin in this cv is mainly methylated: i.e. the 1739 and the 989 cm−1 bands are indicative of methyl esterification (Barros et al. 2002). As in ‘Gala’, other pectin-related bands are affected by inoculation: 1365, 977, 918 and 834 cm−1. Conversely, typical peaks related to phenolic compounds increased after fungal inoculation (Bonora et al. 2009): 1578 and 1184 cm−1. Other features typical of the IR/ATR spectra of inoculated ‘Fuji’ slices are the increase in intensity of bands attributable to hemi-cellulose (1058 and 815 cm−1) and those related to free monosaccharides, in particular to glucose moieties (i.e. 1294, 885 and 777 cm−1) (Schulz and Baranska 2007).
Infrared spectrum of ‘Fuji’ apple fruit at 48 h after inoculation (black 1 spectrum). The blue spectrum is the difference between the inoculated sample at 48 h and its control. Red boxes: peaks attributed to pectin; green boxes: peaks attributed to phenolics; purple boxes: peaks attributed to hemicellulose; black boxes: peaks attributed to glucose
Discussion
The increase of temperatures and the wide variety of commercialized apple cultivars (Di Francesco et al. 2019) are contributing factors in the emergence of different fungal pathogens such as Botriosphaeraceae spp. in Europe (Carlucci et al. 2009; Spagnolo et al. 2011). Between Botryosphaeraceae species, N. parvum and Neofusicoccum luteum resulted the most aggressive (Pérez et al. 2010; Adesemoye et al. 2014; Chen et al. 2014; Delgado-Cerrone et al. 2016).
Our study aimed to characterize the infection mechanism of N. parvum as causal agent of fruit and wood diseases of apple. This fungus is representing a real concern in South America and Europe particularly in Trentino Alto Adige region (Italy), causing severe losses for apple production (Prodorutti et al. 2012; Javier-Alva et al. 2009; Molina-Gayosso et al. 2012; Marques et al. 2013). The present study showed that the pathogenicity of the strain NP1 in apple fruit and wood was highly influenced by the temperature (25 °C/30 °C) and the host chemical composition, especially considering the fruit. In effect, NP1 strain did not show differences of virulence between cultivars in the apple wood colonization. These results can be partially confirmed by Yang et al. (2017), who demonstrated that shoots inoculated with conidia derived from an in vitro production method had larger lesions than those inoculated with conidia from in planta production. In fact, as Amponsah et al. (2008), we could not produce spores by in vitro assays from our N. parvum isolates but only through the twig inoculation.
Conversely between apple fruit cultivars, where ‘Gala’ apples showed a higher susceptibility to N. parvum with respect to “Fuji”, displaying lesion diameters 1.5-fold larger. This finding can be related to a different biochemical response to fungal attack as revealed by ATR/IR spectroscopy. In fact, ‘Fuji’ apples showed a higher content of phenolic compounds compared to the control fruits, while ‘Gala’ showed a decrease of the corresponding IR bands. Boyer and Liu (2004) reported a higher total phenolic and flavonoid content in ‘Fuji’ compared to ‘Gala’ apples. Several reports highlighted the role of phenolic compounds such as ferulic acid and its derivatives in fruit defense response against fungi attack in different crops (Bonora et al. 2009; Lambert et al. 2012; Srivastava et al. 2013). Moreover, the two apple cultivars showed an opposite trend of the pectins esterification degree that is reported to be affected by the fungal attack (Bonora et al. 2009): usually the esterification degree decreases in response to fungal infection by the action of pectin methyl esterases secreted by fungi (Kikot et al. 2009; Vallette-Collet et al. 2003); in fact de-esterification increases the susceptibility of the cell wall structure by favoring the spreading of the attack (Lionetti et al. 2012). Our results showed that ‘Gala’ preferentially displayed the typical peaks of acetylated pectins that increase with time after inoculation, therefore a less effective response to fungi, while ‘Fuji’ showed the typical peaks of methylated pectins. In fact, it is known that the main commercial apple cultivars displayed different susceptibility to pathogens supporting previous data reported by Spotts et al. (1999), where ‘Fuji’ and ‘Granny Smith’ apple were the most resistant varieties to apple fungal pathogens with respect to ‘Gala’ and ‘Golden’ cvs. Overall, significant differences on susceptibility to Botriosphaeriaceae fungi were detected among stone fruit cultivars by Beckman and Reilly (2005) with the cv ‘Summergold’ as the most susceptible and the ‘Redskin’ the least, but no significant differences in virulence between fungal strains were observed in accordance with our results.
Doubtless, N. parvum NP1 strain phytopathogenic behaviour is related to the high production of degradative and oxidative enzymes, often simultaneously secreted (Esteves et al. 2014) such as cellulases and xylanases. Fungi associated with wood diseases may be related to different fungal activities such as the production of phytotoxic compounds (Stempien 2017), and enzymes. As the latter, the enzymatic activities could be associated with the fungal behaviour: low extracellular cellulolytic activities are indicative of a symbiotic lifestyle and low polysaccharide degrading activity accompanied by high proteolytic and lipolytic activities may reflect an adaptation to a non-pathogenic lifestyle (Esteves et al. 2014). In our case, N. parvum was able to degrade the carbohydrate components of cell walls and exhibit mainly cellulase and xylanase activities starting from 3 h after the inoculation, explaining its high and rapid wood decay capability. Furthermore, results showed that our strain particularly exerted xylanase enzyme activity, known to be responsible for the degradation of polysaccharides by Phaeoacremonium minimum (esca disease) (Stempien 2017). These results are confirmed by the increase of IR bands related to free monosaccharides (in particular glucose) that were found in both apple cultivars. Moreover, the increase of hemicellulose bands in ‘Fuji’ spectra could be related to an increased resistance of this cultivar to fungal xylanase activity. On the contrary, pectic and polygalacturonic enzymatic activities, principally involved in the degradation of pectic polymers of fruits and consequence of soft-rot symptoms, were less effective than the above-mentioned cellulase and xylanase enzymes. This fact is probably due to N. parvum ability to shift between endophytic and pathogenic phases (Amponsah et al. 2011; Sakalidis et al. 2011; Baskarathevan et al. 2012; Ramírez-Suero et al. 2012; Fernandes et al. 2014; Abou-Mansour et al. 2015). Mugnai et al. (1999) also described how some fungal secreted compounds in the wood could be translocated to the leaves and fruits, inducing the typical white rot symptoms. Therefore, more investigations on different apple fruit and wood cultivars are necessary also to better clarify the relationship between the increase of fungal virulence and the climate change to prevent the real risk of new epidemics in several geographical regions.
References
Abou-Mansour, E., Débieux, J. L., Ramírez-Suero, M., Bénard-Gellon, M., Magnin-Robert, M., Spagnolo, A., et al. (2015). Phytotoxic metabolites from Neofusicoccum parvum, a pathogen of Botryosphaeria dieback of grapevine. Phytochemistry. https://doi.org/10.1016/j.phytochem.2015.01.012.
Adesemoye, A. O., Mayorquin, J. S., Wang, D. H., Twizeyimana, M., Lynch, S. C., & Eskalen, A. (2014). Identification of species of Botryosphaeriaceae causing bot gummosis in citrus in California. Plant Disease. https://doi.org/10.1094/PDIS-05-13-0492-RE.
Amponsah, N. T., Jones, E. E., Ridgway, H. J., & Jaspers, M. V. (2008). Production of Botryosphaeria species conidia using grapevine green shoots. New Zealand Plant Protection, 61, 310–305.
Amponsah, N. T., Jones, E. E., Ridgway, H. J., & Jaspers, M. V. (2011). Identifcation, potential inoculum sources and pathogenicity of species of the Botryosphaeriaceae associated with grapevine dieback disease in New Zealand. European Journal of Plant Pathology. https://doi.org/10.1071/AP05018.
Ayers, W. A., Papavizas, G. C., Diem, A. F., Durrands, P. K., & Cooper, R. M. (1966). Polygalacturonate transeliminase and polyga-role of pectinases in vascular wilt disease as deterlacturonase production by Rhizoctonia solani. Phytopathology, 56, 1006–1011.
Barros, A. S., Mafra, I., Ferreira, D., Cardoso, S., Reis, A., Lopes de Silva, J. A., et al. (2002). Determination of the degree of methyl esterification of pectic polysaccharides by FT-IR using an outer product PLS1 regression. Carbohydrate Polymers. https://doi.org/10.1016/S0144-8617(02)00017-6.
Baskarathevan, J., Jaspers, M. V., Jones, E. E., & Ridgway, H. J. (2012). Development of isolate-specifc markers for Neofusicoccum parvum and N. luteum and their use to study rainwater splash dispersal in the vineyard. Plant Pathology. https://doi.org/10.1111/j.1365-3059.2012.02675.x.
Beckman, T. G., & Reilly, C. C. (2005). Relative susceptibility of peach cultivars to fungal gummosis (Botryosphaeria dothidea). Journal of the American Pomological Society., 59, 111–116.
Bertsch, C., Ramirez-Suero, M., Magnin-Robert, M., Larignon, P., Chong, J., Abou-Mansour, E., et al. (2013). Grapevine trunk diseases: Complex and still poorly understood. Plant Pathology. https://doi.org/10.1111/j.1365-3059.2012.02674.x.
Bonora, S., Francioso, O., Tugnoli, V., Prodi, A., Di Foggia, M., Righi, V., et al. (2009). Structural characteristics of ‘Hayward’ kiwifruit from elephantiasis-affected plants studied by DRIFT, FT-Raman, NMR, and SEM techniques. Journal of Agricultural and Food Chemistry. https://doi.org/10.1021/jf9002957.
Boyer, J., & Liu, R. H. (2004). Apple phytochemicals and their health benefits. Nutrition Journal. https://doi.org/10.1186/1475-2891-3-5.
Carlucci, A., Lops, F., Raimondo, M. L., Gentile, V., Mucci, M., & Frisullo, S. (2009). The Botryosphaeria species from vineyards of Apulia. Phytopathologia Mediterranea, 48, 180–180.
Chen, S. F., Morgan, D. P., Hasey, J. K., Anderson, K., & Michailides, T. J. (2014). Phylogeny, morphology, distribution, and pathogenicity of Botryosphaeriaceae and Diaporthaceae from English walnut in California. Plant Disease. https://doi.org/10.1094/PDIS-07-13-0706-RE.
Coakley, S. M., Scherm, H., & Chakraborty, S. (1999). Climate change and plant disease management. Annual Review of Phytopathology. https://doi.org/10.1146/annurev.phyto.37.1.399.
Delgado-Cerrone, L., Mondino, P., & Alaniz, S. (2016). Botryosphariaceae species associated with stem canker, die-back and fruit rot on apple in Uruguay. European Journal of Plant Pathology, 146, 637–655. https://doi.org/10.1007/s10658-016-0949-z.
Di Francesco, A., Ugolini, L., D’Aquino, S., Pagnotta, E., & Mari, M. (2017). Biocontrol of Monilinia laxa by Aureobasidium pullulans strains: Insights on competition for nutrients and space. International Journal of Food Microbiology. https://doi.org/10.1016/j.ijfoodmicro.2017.02.007.
Di Francesco, A., Mari, M., & Roberti, R. (2018). Defense response against postharvest pathogens in hot water treated apples. Scientia Horticulturae. https://doi.org/10.1016/j.scienta.2017.09.039.
Di Francesco, A., Cameldi, I., Neri, F., Barbanti, L., Folchi, A., Spadoni, A., & Baraldi, E. (2019). Effect of apple cultivars and storage periods on the virulence of Neofabraea spp. Plant Pathology. https://doi.org/10.1111/ppa.13074.
Durrands, P. K., & Cooper, R. M. (1988). Selection and characterization of pectinase-deficient mutans of the vascular wilt pathogen Verticilliumablo-atrum. Physiological and Molecular Plant Pathology. https://doi.org/10.1016/S0885-5765(88)80029-8.
Eriksson, K., & Petterson, B. (1975). Extracellular enzyme system utilized by the fungus Sporotrichum pulverulentum (Chrysosporium lignorum) for the breakdown of cellulose. European Journal of Biochemistry, 51, 193–206.
Esteves, A. C., Saraiva, M., Correia, A., & Alves, A. (2014). Botryosphaeriales fungi produce extracellular enzymes with 2 biotechnological potential. Canadian Journal of Microbiology. https://doi.org/10.1139/cjm-2014-0134.
Fernandes, I., Alves, A., Correia, A., Devreese, B., & Esteves, A. C. (2014). Secretome analysis identifies potential virulence factors of Diplodia corticola, a fungal pathogen involved in cork oak (Quercus suber) decline. Fungal Biology. https://doi.org/10.1016/j.funbio.2014.04.006.
Hansen, J., Sato, M., Kharecha, P., Russell, G., Lea, D. W., Siddall, M. (2007). Climate change and trace gases. Philosophical transactions. Series A, mathematical, physical, and engineering sciences, https://doi.org/10.1098/rsta.2007.2052.
Heneczowski, M., Kopacz, M., Nowak, D., & Kuzniar, A. (2001). Infrared spectrum analysis of some flavonoids. Acta Poloniae Pharmaceutica, 58, 415–420.
Iotti, M., & Zambonelli, A. (2006). A quick and precise technique for identifying ectomycorrhizas by PCR. Mycological Research, 110, 60–65.
Javier-Alva, J., Gramaje, D., Alvarez, L. A., & Armengol, J. (2009). First report of Neofusicoccum parvum associated with dieback of mango trees in Peru. Plant Disease. https://doi.org/10.1094/PDIS-93-4-0426B.
Khon, F. C., & Hendrix, F. F. (1983). Influence of sugar content and pH on development of white rot on apples. Plant Disease, 67, 410–412.
Kikot, G. E., Hours, R. A., & Alconada, T. M. (2009). Contribution of cell wall degrading enzymes to pathogenesis of Fusarium graminearum: A review. Journal of Basic Microbiology. https://doi.org/10.1002/jobm.200800231.
Lambert, C., Bisson, J., Waffo-Teguo, P., Papastamoulis, Y., Richard, T., Corio-Costet, M. F., et al. (2012). Phenolics and their antifungal role in grapevine wood decay: Focus on the Botryosphaeriaceae family. Journal of Agricultural and Food Chemistry. https://doi.org/10.1021/jf303290g.
Lionetti, V., Cervone, F., & Bellincampi, D. (2012). Methyl esterification of pectin plays a role during plant-pathogen interactions and affects plant resistance to diseases. Journal of Plant Physiology. https://doi.org/10.1016/j.jplph.2012.05.006.
Luque, J., Martos, S., Aroca, A., Raposo, R., & Garcia-Figueres, F. (2009). Symptoms and fungi associated with declining mature grapevine plants in Northeast Spain. Journal of Plant Pathology. https://doi.org/10.4454/jpp.v91i2.968.
Marques, M. W., Lima, N. B., Morais Jr., M. A., Barbosa, M. A. G., Souza, B. O., Michereff, S. J., et al. (2013). Species of Lasiodiplodia associated with mango in Brazil. Fungal Diversity. https://doi.org/10.1007/s13225-013-0231-z.
Melzer, R. R., & Berton, O. (1986). Incidência de Botryosphaeria berengeriana cultura da macieira (Malus domestica) no estado de Santa Catarina, Brasil. Fitopatologia Brasileira., 11, 891–898.
Molina-Gayosso, E., Silva-Rojas, H. V., García-Morales, S., & Avila-Quezada, G. (2012). First report of black spots on avocado fruit caused by Neofusicoccum parvum in Mexico. Plant Disease. https://doi.org/10.1094/PDIS-08-11-0699.
Mugnai, L., Surico, G., & Sfalanga, A. (1997). Produzione di enzimi esocellulari da parte di funghi del legno di viti colpite da “mal dell’esca”. Micologia italiana., 1, 11–22.
Mugnai, L., Graniti, A., & Surico, G. (1999). Esca (black measles) and brown wood streaking two old and elusive diseases of grapevines. Plant Disease. https://doi.org/10.1094/PDIS.1999.83.5.404.
Pérez, C. A., Wingfield, M. J., Slippers, B., Altier, N. A., & Blanchette, R. A. (2010). Endophytic and canker-associated Botryosphaeriaceae occurring on non-native Eucalyptus and native Myrtaceae trees in Uruguay. Fungal Diversity. https://doi.org/10.1007/s13225-009-0014-8.
Phillips, A. J. L., Alves, A., Abdollahzadeh, J., Slippers, B., Wingfield, M. J., Groenewald, J. Z., et al. (2013). The Botryosphaeriaceae: Genera and species known from culture. Studies in Micology. https://doi.org/10.3114/sim0021.
Prodorutti, D., Cainelli, C., Gualandri, V., Profaizer, D., Dallago, A., Branz, A., et al. (2012). Moria e deperimento del melo in Trentino. Atti Giornate Fitopatologiche, 2, 619–620.
Ramírez-Suero, M., Chong, J., Farine, S., Kiefe-Mazet, F., Pensec, F., Gacougnole, I., et al. (2012). Effect of Neofusicoccum parvum and Diplodia seriata extra-cellular compounds on defence gene expression in Vitis vinifera cv. Chardonnay and cv. Gewurztraminer. Phytopathologia Mediterranea, 51, 438–438.
Sakalidis, M. L., Hardy, G. E. S. J., & Burgess, T. I. (2011). Class III endophytes, clandestine movement amongst hosts and habitats and their potential for disease; a focus on Neofusicoccum australe. Australasian Plant Pathology, 40, 510–521. https://doi.org/10.1007/s13313-011-0077-3.
Sakalidis, M. L., Slippers, B., Wingfield, B. D., G. E. St. J. Hardy, Burgess, T. I. (2013). The challenge of understanding the origin, pathways and extent of fungal invasions: global populations of the Neofusicoccum parvum–N. ribis species complex. Diversity and Distributions, https://doi.org/10.1111/ddi.12030.
Schneider, C. A., Rasband, W. S., & Eliceiri, K. W. (2012). NIH image to ImageJ: 25 years of image analysis. Nature Methods, 9, 671–675 PMID: 22930834.
Schulz, H., & Baranska, M. (2007). Identification and quantification of valuable plant substances by IR and Raman spectroscopy. Vibrational Spectroscopy. https://doi.org/10.1016/j.vibspec.2006.06.001.
Slippers, B., & Wingfield, M. J. (2007). Botryosphaeriaceae as endophytes and latent pathogens of woody plants: Diversity, ecology and impact. Fungal Biology Reviews. https://doi.org/10.1016/j.fbr.2007.06.002.
Slippers, B., Smit, A., Crous, P. W., Countinho, T. A., Wingfield, B. D., & Wingfield, M. J. (2007). Taxonomy, phylogeny and identification of Botryosphaeriaceae associated with pome and stone fruit trees in South Africa and other regions of the world. Plant Pathology. https://doi.org/10.1111/j.1365-3059.2006.01486.x.
Slippers, B., Boissin, E., Phillips, A. J. L., Groenewald, J. Z., Wingfield, M. J., Postma, A., et al. (2013). Phylogenetic lineages in the Botryosphaeriales: A systematic and evolutionary framework. Studies in Mycology, https://doi.org/10.3114/sim0020.
Spagnolo, A., Marchi, G., Peduto, F., Phillips, A. J. L., & Surico, G. (2011). Detection of Botryosphaeriaceae species within grapevine woody tissues by nested PCR, with particular emphasis on the Neofusicoccum parvum/N. ribis complex. European Journal of Plant Pathology. https://doi.org/10.1007/s10658-010-9715-9.
Spagnolo, A., Larignon, P., Magnin-Robert, M., Hovasse, A., Cilindre, C., Van Dorsselaer, A., et al. (2014). Flowering as the most highly sensitive period of grapevine (Vitis vinifera L. cv Mourvèdre) to the Botryosphaeria dieback agents Neofusicoccum parvum and Diplodia seriata infection. International Journal of Molecular Sciences. https://doi.org/10.3390/ijms15069644.
Spotts, R. A., Cervantes, L. A., & Mielke, E. A. (1999). Variability in postharvest decay among apple cultivars. Plant Disease. https://doi.org/10.1094/PDIS.1999.83.11.1051.
Srivastava, P., Andersen, P. C., Marois, J. J., Wright, D. L., Srivastava, M., & Harmon, P. F. (2013). Effect of phenolic compounds on growth and ligninolytic enzyme production in Botryosphaeria isolates. Crop Protection. https://doi.org/10.1016/j.cropro.2012.09.015.
St Leger, R. J., Joshi, L., & Roberts, D. W. (1997). Adaptation of proteases and carbohydrases of saprophytic: Phytopathogenic and entomopathogenic fungi to the requirements of their ecological niches. Microbiology, 143, 1983–1992.
Stempien, E. (2017). Grapevine Botryosphaeria dieback fungi have specific aggressiveness factor repertory involved in wood decay and stilbene metabolization. PLoS One. https://doi.org/10.1371/journal.pone.0188766.
Synytsya, A., Copikova, J., Matejka, P., & Machovic, V. (2003). Fourier transform Raman and infrared spectroscopy of pectins. Carbohydrate Polymers. https://doi.org/10.1016/S0144-8617(03)00158-9.
Taylor, A., Hardy, G. E. St. J., Wood, P., & Burgess, T. (2005). Identification and pathogenicity of Botryosphaeria species associated with grapevine decline in Western Australia. Australasian Plant Pathology. https://doi.org/10.1071/AP05018.
Úrbez-Torres, J. R. (2011). The status of Botryosphaeriaceae species infecting grapevines. Phytopathologia Mediterranea. https://doi.org/10.14601/Phytopathol_Mediterr-9316.
Vallette-Collet, O., Cimerman, A., Reignault, P., Levis, C., & Boccara, M. (2003). Disruption of Botrytis cinerea pectin methyl esterase gene Bcpme I reduces virulence on several host plants. Molecular Plant-Microbe Interactions. https://doi.org/10.1094/MPMI.2003.16.4.360.
Yang, Y. L., Turner, J., Stephens, J., Campbell, R. E., & Walter, M. (2017). Comparison of in vitro and in planta sporogenesis in Neofusicoccum species from blueberry. New Zealand Plant Protection, 70, 203–208.
Author information
Authors and Affiliations
Corresponding author
Ethics declarations
Conflict of interest
This work was not financed by grants. The authors declare no conflict of interest. This article does not contain any work conducted on animal or human participants.
Rights and permissions
About this article
Cite this article
Di Francesco, A., Rusin, C., Di Foggia, M. et al. Characterization of apple cultivar susceptibility to Neofusicoccum parvum Brazilian strains. Eur J Plant Pathol 156, 939–951 (2020). https://doi.org/10.1007/s10658-020-01945-7
Accepted:
Published:
Issue Date:
DOI: https://doi.org/10.1007/s10658-020-01945-7